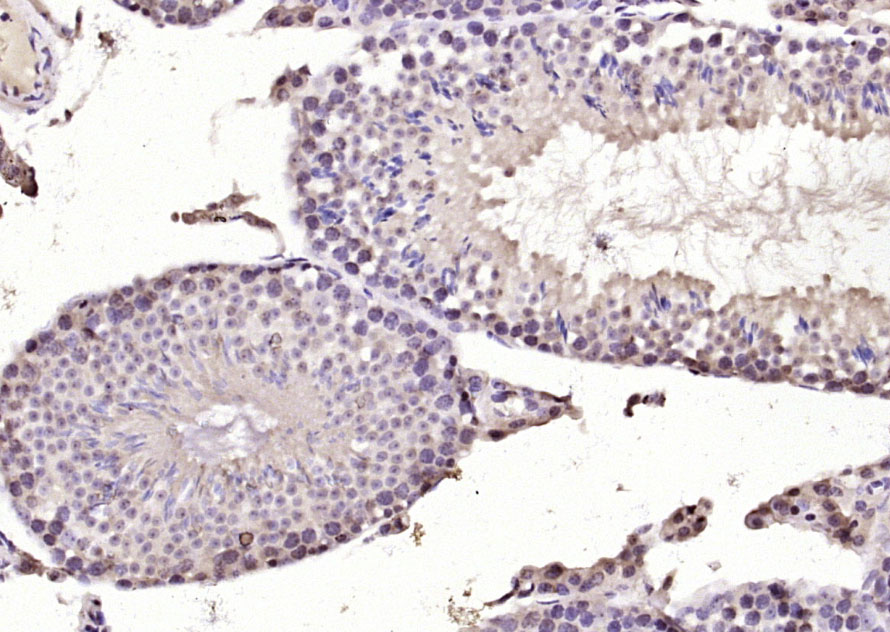
DYRK2 Rabbit pAb(bs-12332R)-50

相关产品推荐更多 >
万千商家帮你免费找货
0 人在求购买到急需产品
- 详细信息
- 技术资料
- 应用范围:
产品信息以Bioss网站为准
- 规格:
50ul/100ul/200ul
| 规格: | 50ul | 产品价格: | ¥1180.0 |
|---|---|---|---|
| 规格: | 100ul | 产品价格: | ¥1980.0 |
| 规格: | 200ul | 产品价格: | ¥2800.0 |
| 产品编号 | bs-12332R |
| 英文名称 | DYRK2 Rabbit pAb |
| 中文名称 | 双特异性酪氨酸磷酸化调节激酶DYRK2抗体 |
| 英文别名 | 1810038L18Rik; Dual specificity tyrosine(Y) phosphorylation regulated kinase 2; Dual specificity tyrosine phosphorylation regulated kinase 2; Dual specificity tyrosine-phosphorylation-regulated kinase 2; DYRK2; DYRK2_HUMAN; EC 2.7.12.1; FLJ21217; FLJ21365. |
| 产品应用 | IHC-P=1:100-500, IHC-F=1:100-500, IF=1:100-500 Not yet tested in other applications. |
| 交叉反应 | Mouse, Rat (Human, Dog, Pig, Cow, Horse, Rabbit) |
| 抗体来源 | Rabbit |
| 免疫原 | KLH conjugated synthetic peptide derived from human DYRK2 |
| 亚型 | IgG |
| 性状 | Liquid |
| 纯化方法 | affinity purified by Protein A |
| 克隆类型 | Polyclonal |
| 理论分子量 | 67 kDa |
| 浓度 | 1mg/ml |
| 储存液 | 0.01M TBS (pH7.4) with 1% BSA, 0.02% Proclin300 and 50% Glycerol. |
| 研究领域 | Signal Transduction > Protein Phosphorylation > Ser / Thr Kinases > Other Kinases Signal Transduction > Protein Phosphorylation > Tyrosine Kinases |
| 亚基 | Component of an E3 ligase complex containing DYRK2, EDD/UBR5, DDB1 and VPRBP (EDVP complex). Interacts directly with EDD/UBR5, DDB1 and VPRBP. Interacts with SIAH2 and MDM2. Interacts with MAP3K10 and NFATC1. May also interact with CCNL2. |
| 亚细胞定位 | Cytoplasm. Nucleus. Translocates into the nucleus following DNA damage. |
| 组织特异性 | Testis, after the onset of spermatogenesis. |
| 翻译后修饰 | Autophosphorylates cotranslationally on the second tyrosine residue in the Tyr-X-Tyr motif in the activation loop, but once mature, does not have any protein tyrosine kinase activity. Phosphorylated at Thr-106 and Ser-442 by ATM in response to genotoxic stress. Under normal conditions, polyubiquitinated in the nucleus by MDM2, leading to its proteasomal degradation. Phosphorylation on Thr-106 and Ser-442 by ATM in response to genotoxic stress disrupts MDM2 binding and prevents MDM2-mediated ubiquitination and subsequent proteasomal degradation. Polyubiquitinated by SIAH2, leading to its proteasomal degradation. Polyubiquitinated by SIAH2 occurs under normal conditions, and is enhanced in response to hypoxia. |
| 相似性 | Belongs to the protein kinase superfamily. CMGC Ser/Thr protein kinase family. MNB/DYRK subfamily. Contains 1 protein kinase domain. |
| 功能 | Role in the regulation of cellular growth and/or development. Regulates TP53 by phosphorylation on Ser-46 to induce apoptosis in response to DNA damage, functioning downstream of ATM. Inactivates GYS1 by phosphorylation at Ser-641, and potentially also a second phosphorylation site, thus regulating glycogen synthesis. Phosphorylates EIF2B5 at Ser-544, enabling its subsequent phosphorylation and inhibition by GSK3, and may play a more general role in the priming of GSK3 substrates. |
| 保存条件 | Shipped at 4℃. Store at -20℃ for one year. Avoid repeated freeze/thaw cycles. |
| 注意事项 | This product as supplied is intended for research use only, not for use in human, therapeutic or diagnostic applications. |
| 背景资料 | Dyrk is the homolog of the Drosophila mnb (minibrain) gene, which is required for neurogenesis (1–3). Dyrk is a dual-specificity tyrosine kinase and serine/threonine kinase, which is itself regulated by tyrosine phosphorylation (1). Several mammalian Dyrk related proteins have been identified and are thought to compose a family of dual specificity protein kinases (4). Dyrk family members, including Dyrk1A (originally Dyrk), Dyrk1B, Dryk1C, Dyrk2, Dyrk3, Dyrk4A and Dyrk4B, are thought to be involved in diverse cellular functions (4). Dyrk1A is a candidate gene that may be involved in Downs syndrome, and it has been found to be somewhat overexpressed in Downs syndrome (1,5). Two isoforms of human fetal brain Dyrk2 exist: a deduced 528-amino acid protein and a protein containing 73 additional amino acids at the amino terminus (4). Dyrk3 is strongly expressed in testis, only after the onset of spermatogenesis, and very weakly expressed in spleen and adrenal gland (1). The genes which encode Dyrk2 and Dyrk3 map to human chromosomes 12 and 1q32, respectively (4). |
| 应用 | 推荐稀释比例 |
| {IHC-P} | {1:100-500} |
| {IHC-F} | {1:100-500} |
| {IF} | {1:100-500} |
Paraformaldehyde-fixed, paraffin embedded (mouse testis); Antigen retrieval by boiling in sodium citrate buffer (pH6.0) for 15min; Block endogenous peroxidase by 3% hydrogen peroxide for 20 minutes; Blocking buffer (normal goat serum) at 37°C for 30min; Antibody incubation with (DYRK2) Polyclonal Antibody, Unconjugated (bs-12332R) at 1:200 overnight at 4°C, followed by operating according to SP Kit(Rabbit) (sp-0023) instructionsand DAB staining.

Paraformaldehyde-fixed, paraffin embedded (rat testis); Antigen retrieval by boiling in sodium citrate buffer (pH6.0) for 15min; Block endogenous peroxidase by 3% hydrogen peroxide for 20 minutes; Blocking buffer (normal goat serum) at 37°C for 30min; Antibody incubation with (DYRK2) Polyclonal Antibody, Unconjugated (bs-12332R) at 1:200 overnight at 4°C, followed by operating according to SP Kit(Rabbit) (sp-0023) instructionsand DAB staining.
风险提示:丁香通仅作为第三方平台,为商家信息发布提供平台空间。用户咨询产品时请注意保护个人信息及财产安全,合理判断,谨慎选购商品,商家和用户对交易行为负责。对于医疗器械类产品,请先查证核实企业经营资质和医疗器械产品注册证情况。
技术资料暂无技术资料 索取技术资料
DYRK2 Rabbit pAb(bs-12332R)-50ul/100ul/200ul
¥1180 - 2800








